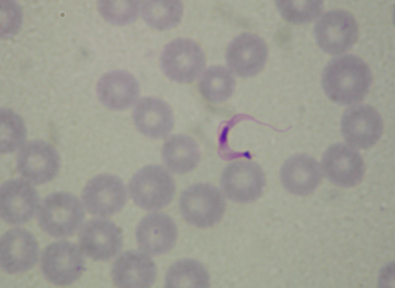
<p>What is this organism?</p>
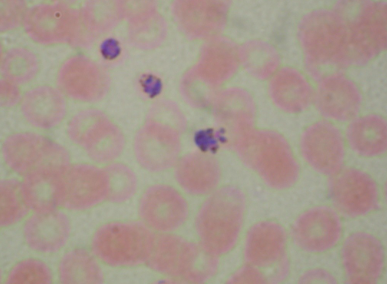
<p>what organism is this?</p>
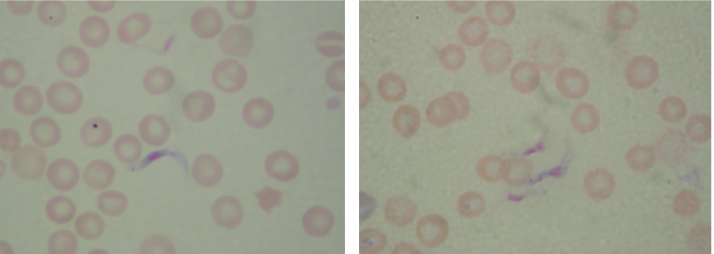
<p>what organism is this?</p>

Protozoan parasites
1/11
There's no tags or description
Looks like no tags are added yet.
Name | Mastery | Learn | Test | Matching | Spaced | Call with Kai |
|---|
No analytics yet
Send a link to your students to track their progress
12 Terms
Name the causative agent, vector, endemic location, transmission, and signs and symptoms of Changa’s disease
Etiological agent: Trypanosoma cruzi
Vector: Rhodnius or the assassin bug
Endemic to Mexico, Central and South America, and Souther USA (Texas)
Transmitted when Rhodnius bites a person and defecates while doing so, then the person scratches the bite and rubs the parasite into the wound
Symptoms: Severe in children under 5 (anemia, muscle pain, nerve disorders), mild in adults (swelling around eyes, muscle aches, if it spreads to the CNS it can cause paralysis or death)
Name the causative agent, vector, endemic location, transmission, and signs and symptoms of Leishmaniasis
Etiological agent: Leishmania
Vector: sandfly
Endemic location: Saudi Arabia, Iran, and Iraq
Transmission: Sandfly bites a person and injects the parasite into their blood
Symptoms: Visceral Leishmanias may cause high fever, weakness, or wasting, Cutaneous Leishmanias may cause skin lesions or scaring from those lesions
Name the causative agent, vector, endemic location, transmission, and signs and symptoms of Malaria
Etiological agent: Plasmodium vivax or Plasmodium falciparum
Vector: female Anopheles mosquito
Endemic location: Africa and India
Transmission: The female mosquito bites a person and injects the parasite into their blood during feeding
Symptoms: Plasmodium causes RBC to rupture causing chills, fever, anemia, or jaundice. Damaged RBC may clog capillaries leading to stroke or kidney damage
Name the causative agent, vector, endemic location, transmission, and signs and symptoms of African sleeping sickness (the worst of the bunch)
Etiological agent: Trypanosoma gambiense
Vector: tsetse fly
Endemic location: Africa
Transmission: tsetse fly bites a person and injects the parasite into their blood
Symptoms: asymptomatic for 1-2 weeks, swollen sore at injection site, once the parasite enters the blood may cause fever, weakness, or anemia. CNS involvement causes swollen lymph nodes, constant sleeping, convulsions, coma, and death.

Name the parasite-vector pair. What disease do they cause? How and where is it transmitted? What are the symptoms?
Parasite and Vector: T. Cruzi and Rhodnius (assassin bug/kissing bug)
Disease: Chaga’s disease
Typically found in Mexico, Central and South America, and Southern USA.
Transmitted when the vector bites and defecates on the host. When the host scratches the bite it rubs the parasite into the wound
Children under 5 show severe symptoms like anemia, muscle pain and nerve disorder
Adults may have swelling around their eyes, muscle aches, or paralysis and death if it gets into the CNS

Name the parasite-vector pair. What disease do they cause? How and where is it transmitted? What are the symptoms?
Parasite and vector: Leishmania and the sandfly
Disease: Leishmaniasis
Found in countries like Saudi Arabia, Iran, and Iraq, transmitted by the vector biting the host and injecting the parasite into their blood
Visceral Leishmaniasis causes high fever, weakness, wasting, and abdominal protrusion, may be fatal
Cutaneous Leishmaniasis causes skin lesions that may scar

Name the parasite-vector pair. What disease do they cause? How and where is it transmitted? What are the symptoms?
Parasite and vector: female Anopheles mosquito and Plasmodium vivax or P.falciparum
Disease: Malaria
Found in Africa and India, transmitted by mosquito biting the host during feeding and injecting the parasite
Plasmodium attacks RBC and causes lysis, leading to anemia, chills, fever, jaundice or capillaries may fill with RBC leading to stroke, brain or kidney damage

Name the parasite-vector pair. What disease do they cause? How and where is it transmitted? What are the symptoms?
Parasite and vector: Trypanosoma gambiense and tsetse fly
Disease: African sleeping sickness
Found in Africa, spread when the fly bites the host, injecting the parasite
Asymptomatic for the 1st 2 weeks, causes a swollen sore at the injection sites, then fever, weakness, and anemia when the parasite enters the blood. Once in the CNS, the host’s lymph nodes enlarge, they may feel sleepy, experience convulsions, or death
What is this organism?
Trypanosoma cruzi

what organism is this?
Leishmania
what organism is this?
Plasmodium vivax
what organism is this?
Trypanosoma gambiense